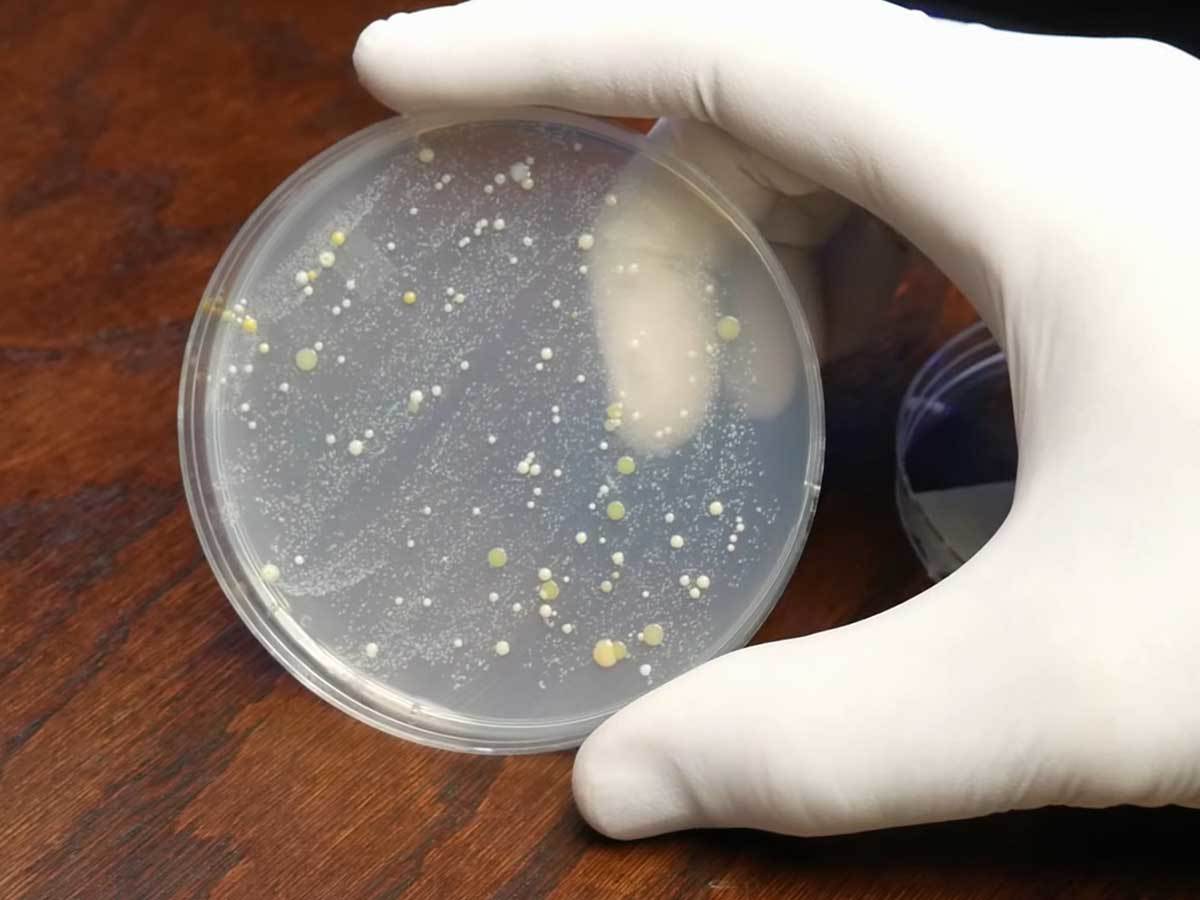

Naučite kako da pravilno održavate svoj telefon lepšim za oko i bezbednijim za zdravlje, a da ga ne oštetite neadekvatnim hemijskim sredstvima.

Od svih uređaja koje svakodnevno koristite, pametni telefon je sigurno na vrhu liste kada je reč o omiljenom uređaju bez kojeg ne možete da zamislite svoj dan. Komunikacija sa drugima, informacije dostupne u svakom trenutku, uživanje u omiljenim aplikacijama, lako beleženje važnih, lepih, spontanih momenata - samo su neke od stvari zbog kojih nigde ne idete bez telefona.
Baš iz razloga što je mobilni telefon uvek uz vas, tokom samo jednog dana on može da završi na mnogim mestima. Telefon držite u džepu, torbi, jakni, ostavljate ga na raznim površinama, a često se nalazi i blizu hrane, gde može lako da se izmasti. Kako sva ta mesta omogućavaju da telefon pokupi razne bakterije i nečistoće, važno je redovno čišćenje pametnog telefona.
Treba napomenuti da ćete čišćenjem ukloniti nečistoće sa svog uređaja, ali ne i mikroorganizme koji, naravno, nisu vidljivi okom. Zato se preporučuje i redovna dezinfekcija pametnog telefona, a o svemu će biti reči u nastavku teksta.
Koliko često treba čistiti i dezinfikovati telefon
Čišćenje pametnog telefona ne morate obavljati svakog dana, ali dezinfekcija pametnog telefona je veoma važna i preporučljivo je da svakodnevno dezinfikujete svoj telefon. Na taj način ćete sprečiti da razne štetne bakterije i drugi mikroorganizmi završe na vašem licu, telu i u vašem organizmu.
Šta podrazumeva čišćenje pametnog telefona
Možda na prvi pogled deluje da je odgovor na ovo pitanje jednostavan, ali čišćenje pametnog telefona ne podrazumeva samo uklanjanje nečistoća sa čitave površine telefona. Pored ovoga, važno je ukloniti i nečistoće koje su zaglavljene u rupicama i usecima na telefonu, kao što su rešetka ili mrežica zvučnika, prostor između tastera i kućišta telefona, konektori itd.
Šta bi trebalo da uradite pre nego što započnete čišćenje pametnog telefona
Ukoliko imate masku na telefonu, skinite je i dezinfikujte je alkoholom (ne veće koncentracije od 70%) ili asepsolom. Jednostavno je: sipajte ili naprskajte malo tečnosti na mikrofiber krpu, vatu ili tupfer i detaljno obrišite spoljašnost i unutrašnjost maske.
Zatim blago otresite rukom sve mrvice i slične nečistoće koje su se nakupile između maske i telefona i zadržale na površini uređaja. Ove nečistoće mogu biti veoma tvrde i lako mogu ogrebati površinu telefona, zbog čega se ne preporučuje da telefon trljate krpom pre nego što nežno uklonite krupnije nečistoće.
Kako očistiti ekran mobilnog telefona
Ekran telefona je najviše podložan tome da se isprlja, dok su drugi delovi telefona uglavnom zaštićeni maskom. Na ekranu telefona se mogu pronaći tragovi otisaka prstiju, razne fleke, ostaci šminke ili ulja za bradu, ponekad i ostaci hrane, pa čak i fekalne materije. Nauka kaže da je ekran mobilnog telefona prljaviji od daske na WC-šolji.
Ukoliko ekran vašeg mobilnog telefona nije previše zaprljan, možete jednostavno da ga očistite specijalnom krpom za ekran (mikrofiber krpa), koja će efikasno ukloniti tragove otisaka prstiju, prašinu i manje fleke. Ekran možete da prebrišete i krpicom ili maramicama za brisanje naočara. Prostor oko tastera možete da obrišete i štapićima za uši.
U slučaju da je ekran vašeg mobilnog telefona prilično prljav ili zamašćen, možete ga detaljno očistiti na nekoliko načina:
- Destilovanom vodom ili sredstvom posebno namenjenim za čišćenje telefona. Na mnogim telefonima se nalazi poseban oleofobski premaz koji smanjuje zadržavanje otisaka prstiju. Neadekvatna hemijska sredstva često oštete ovaj premaz, pa telefon izgleda flekavo. Zbog toga je za čišćenje telefona najbolje koristiti destilovanu vodu ili specijalizovana sredstva za čišćenje.
- Nanesite malo destilovane vode ili sredstva za čišćenje na mikrofiber krpu i obrišite ekran. Važno je da znate da nijedna od tih tečnosti nije testirana na apsolutno svakom modelu telefona, pa prvo isprobajte sredstvo na nekom manje vidljivom delu telefona.
Mešavinom destilovane vode i alkoholnog sirćeta. Uzmite manju bocu sa raspršivačem i napunite je do pola vodom, a od pola do vrha sipajte alkoholno (belo) sirće. Potom naprskajte ili blago natopite mikrofiber krpu ovim rastvorom i detaljno prebrišite ekran.- Ukoliko nemate bocu sa raspršivačem ili želite samo malu količinu rastvora za jedno čišćenje, sipajte 50% vode i 50% alkoholnog sirćeta u šoljicu.
Mešavinom destilovane vode i alkohola. Biće vam potrebna bočica sa raspršivačem ili šoljica. U tri četvrtine bočice ili šoljice sipajte alkohol (ne veće koncentracije od 70%), a u preostalu četvrtinu sipajte destilovanu vodu. Potom naprskajte ili blago pokvasite mikrofiber krpu i detaljno obrišite ekran. Ostavite telefon da se potpuno osuši i uključite ga.
Napomena: Destilovanu vodu, sredstvo ili rastvor za čišćenje mobilnog telefona nikada ne nanosite direktno na telefon kako ga ne biste oštetili. Uvek prvo nanesite na krpu, pa tek onda obrišite telefon.
Kako očistiti zadnji deo telefona i kameru
S obzirom na to da je poleđina telefona uglavnom deo zaštićen maskom, dovoljno je da je detaljno obrišete mikrofiber krpom, nakon što skinete masku. Budite posebno pažljivi kod brisanja sočiva kamera, kako ih ne biste izgrebali.
Imajte u vidu da alkohol i hemijska sredstva za čišćenje telefona mogu da ostave tanak film na sočivima kamera, zbog kojeg će fotografije izgledati lošije. S tim u vezi, preporuka je da sočiva čistite suvom mikrofiber krpom.
Ukoliko zadnja strana vašeg telefona zahteva ozbiljnije čišćenje, možete da ponovite isti postupak kao kod čišćenja ekrana telefona.
Kako očistiti priključak za punjač, priključak za slušalice, mikrofon i zvučnik telefona

Delovi kojima se posvećuje najmanje pažnje prilikom čišćenja mobilnog telefona jesu delovi gde su smešteni mikrofon, zvučnik i konektori. U ovim rupicama može da se nataloži dosta prljavštine, pa tako može da se dogodi da npr. ne možete lepo da ubacite konektor punjača ili da konektor punjača često ispada iz telefona. Zbog toga je važno da, kada je čišćenje pametnog telefona u pitanju, ne preskačete ove sitne, ali izuzetno važne delove.
Priključak za punjač, priključak za slušalice, kao i kao mikrofon i zvučnike telefona je najbolje očistiti kompresovanim vazduhom u boci, koji možete kupiti u svakoj bolje snabdevenoj prodavnici tehničke robe.
I u ovom slučaju prvo skinite masku i isključite telefon, a potom bocu sa kompresovanim vazduhom usmerite ka delu iz kojeg želite da izduvate nečistoće i kontrolisano, najpre sa većeg odstojanja, ispuštajte vazduh iz boce. Preporuka je da bocu držite uspravno i da vazduh ispuštate kroz više kratkih pritisaka, kako biste sprečili pojavu vlage usled kondenzacije i kako biste održali pritisak u boci.
Napomena: S obzirom na to da postoji mogućnost pojave vlage usled kondenzacije, nakon čišćenja telefona kompresovanim vazduhom sačekajte 15 minuta pa tek onda uključite telefon, kako biste bili sigurni je telefon potpuno suv.
Može se dogoditi da kompresovani vazduh ne može da ukloni sve nečistoće, pogotovo ukoliko su one čvrsto zalepljene ili zaglavljene u telefonu. Ukoliko se susretnete sa ovim problemom, pokušajte vrhom čačkalice da uklonite nečistoće, ali to uradite veoma pažljivo kako ne biste oštetili telefon.
Kako dezinfikovati mobilni telefon
Mobilni telefon svakodnevno pokupi mnoštvo bakterija i prljavštine koji mogu da dovedu do raznih problema sa kožom i da pospeše razvoj virusa. Zbog toga je važno da se svakodnevno obavlja dezinfekcija pametnog telefona. Dezinfekcija podrazumeva uklanjanje mikroorganizama, za šta možete da koristite specijalizovane tečnosti za dezinfekciju telefona, rastvor koji ste sami napravili ili posebne UV kutije za dezinfekciju mobilnih telefona.
Koristite alkohol samo u krajnjoj nuždi
Dezinfekcija mobilnog telefona alkoholom se ne preporučuje. Naime, u svrhu dezinfekcije bi trebalo da koristite alkohol koncentracije 70%, jer razblažen ne bi bio dovoljno efikasan, ali takav alkohol može (u ređim slučajevima) da ošteti boju na vašem telefonu, zaštitnu foliju na ekranu ili oleofobski premaz koji se nalazi na ekranu i poleđini telefona, a čiji je zadatak da smanji zadržavanje otisaka prstiju i drugih nečistoća.

Alkoholom konrentracije 70% možete dezinfikovati masku, tako što ćete mikrofiber krpu, vatu ili tupfer navlažiti alkoholom i preći preko svih spoljašnjih i unutrašnjih delova maske za telefon. Pre nego što masku vratite na telefon, sačekajte da se potpuno osuši.
Dezinfekcija mobilnog telefona sapunicom
Uzmite manju posudu i napunite je vodom, a potom sipajte malo tečnog sapuna ili na kratko ubacite čvrst sapun kako bi se napravila sapunica. Potom blago navlažite mikrofiber krpu sapunicom i detaljno prebrišite telefon, koji ste prethodno isključili i sa kog ste skinuli masku.
Izbegavajte da prelazite preko delova u koje može da uđe voda, kao što su zvučnik, mikrofon i priključci za punjač i slušalice. Nakon dezinfekcije, pažljivo prebrišite telefon čistom, suvom krpom.
Dezinfekcija mobilnog telefona pomoću UV kutije

UV kutije za dezinfekciju mobilnih telefona su male, specijalizovane kutije u koje može da se stavi telefon dijagonale ekrana do 6,9 inča, mada postoje i veće UV kutije koje omogućavaju i dezinfekciju tablet uređaja.
Ove posebne UV kutije ubijaju i do 99,9 posto bakterija i mikroorganizama za veoma kratko vreme i predstavljaju odlično rešenje ukoliko ne želite da tretirate telefon raznim tečnim sredstvima za dezinfekciju. Naravno, korišćenje UV kutije ne zamenjuje redovno čišćenje mobilnog telefona.
Sada znate kako treba da obavljate čišćenje mobilnog telefona obavljate detaljno, a proces je zaista jednotavan i ne zahteva mnogo vremena, pogotovo ako telefon redovno čistite. Redovno čišćenje i svakodnevna dezinfekcija mobilnog telefona smanjiće štetan uticaj bakterija na vaš organizam, a elektronski ljubimac će u svakoj prilici izgledati reprezentativno.
Postanite deo SMARTLIFE zajednice na Viberu.